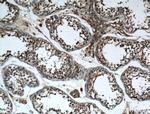
ARL3 Antibody in Immunohistochemistry (Paraffin) (IHC (P))
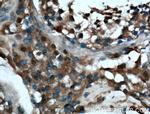
ARL3 Antibody in Immunohistochemistry (Paraffin) (IHC (P))

Search
Proteintech
ARL3 Polyclonal Antibody
{{$productOrderCtrl.translations['antibody.pdp.commerceCard.promotion.promotions']}}
{{$productOrderCtrl.translations['antibody.pdp.commerceCard.promotion.viewpromo']}}
{{$productOrderCtrl.translations['antibody.pdp.commerceCard.promotion.promocode']}}: {{promo.promoCode}} {{promo.promoTitle}} {{promo.promoDescription}}. {{$productOrderCtrl.translations['antibody.pdp.commerceCard.promotion.learnmore']}}

Please note: We are reviewing Western blot images included in the antibody testing data in our catalog, including those provided by third parties. Unless expressly labeled or annotated as “raw-unedited”, Western blot images included in the antibody testing data in our catalog may have been edited, optimized or otherwise adjusted for presentation.
产品信息
10961-1-AP
种属反应
已发表种属
宿主/亚型
分类
类型
抗原
偶联物
形式
浓度
规格
纯化类型
保存液
内含物
保存条件
运输条件
产品详细信息
Immunogen sequence: MGLLSILRK LKSAPDQEVR ILLLGLDNAG KTTLLKQLAS EDISHITPTQ GFNIKSVQSQ GFKLNVWDIG GQRKIRPYWK NYFENTDILI YVIDSADRKR FEETGQELAE LLEEEKLSCV PVLIFANKQD LLTAAPASEI AEGLNLHTIR DRVWQIQSCS ALTGEGVQDG MNWVCKNVNA KKK (1-182 aa encoded by BC009841)
靶标信息
ADP-ribosylation factors (ARFs) are low molecular weight GTP-binding proteins belonging to the RAS superfamily. The predicted 182-amino acid ARL3 (ADP-ribosylation like factor) protein shares 97% amino acid identity with rat ARLl3 and 43% identity with human ARF1. Like the ARFs, ARL3 has a glycine at position 2, the site of N myristoylation, and lacks cysteine residues near the C terminus, which are found in other members of the RAS family. Northern blot analysis detected a 1-kb ARL3 transcript in all tissues tested, with highest expression in heart and lung, and lower expression in brain, liver, kidney, ovary, and testis. A 5.5-kb transcript was also detected in most tissues, with highest expression in brain. Immunoblot analysis detected ARL3 in human tumor cell lines but not in normal rodent cells. Although ARL3 binds GTP, it is devoid of activity in the cholera toxin-dependent ADP-ribosylation of Gs, and is therefore classified as an ARF-like protein.
仅用于科研。不用于诊断过程。未经明确授权不得转售。
生物信息学
蛋白别名: ADP-ribosylation factor-like protein 3; ADP-ribosylation-like 3; ARD3; Arf-like protein 3
基因别名: ARFL3; ARL3
UniProt ID: (Rat) P37996, (Mouse) Q9WUL7
Entrez Gene ID: (Rat) 64664, (Mouse) 56350




